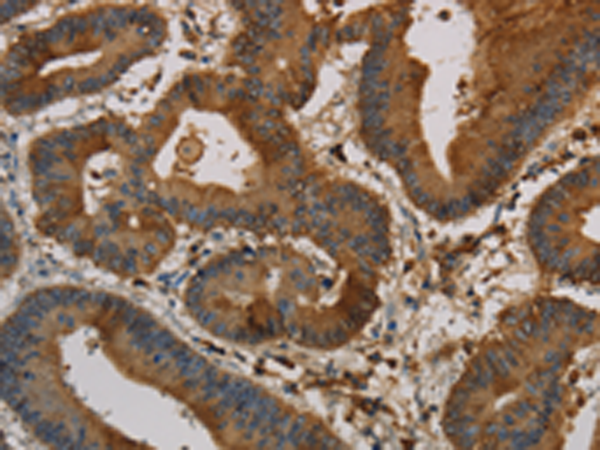
一抗

|
Background: |
The protein encoded by this gene is a member of the keratin gene family. The keratins are intermediate filament proteins responsible for the structural integrity of epithelial cells and are subdivided into cytokeratins and hair keratins. Most of the type I cytokeratins consist of acidic proteins which are arranged in pairs of heterotypic keratin chains and are clustered in a region of chromosome 17q12-q21. This keratin has been coexpressed with keratin 14 in a number of epithelial tissues, including esophagus, tongue, and hair follicles. Mutations in this gene are associated with type 1 pachyonychia congenita, non-epidermolytic palmoplantar keratoderma and unilateral palmoplantar verrucous nevus. |
|
Applications: |
ELISA, WB, IHC |
|
Name of antibody: |
KRT16 |
|
Immunogen: |
Synthetic peptide of human KRT16 |
|
Full name: |
keratin 16 |
|
Synonyms: |
K16; CK16; K1CP; NEPPK; FNEPPK; KRT16A |
|
SwissProt: |
P08779 |
|
ELISA Recommended dilution: |
2000-5000 |
|
IHC positive control: |
Human colon cancer and Human liver cancer |
|
IHC Recommend dilution: |
50-200 |
|
WB Predicted band size: |
51 kDa |
|
WB Positive control: |
Hela cells |
|
WB Recommended dilution: |
500-2000 |


 購物車
購物車 幫助
幫助
 021-54845833/15800441009
021-54845833/15800441009